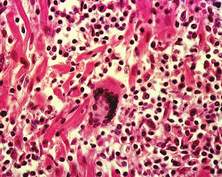

Bố tôi năm nay 64 tuổi, bị bệnh tim 10 năm nay, vừa qua phải nhập viện, các bác sĩ nói bị suy tim tâm thu, tôi không hiểu đây là bệnh tim như thế nào, có nguy hiểm không? Xin quý báo giải thích giúp?
Phạm Duy (Thái Bình)
Suy tim tâm thu là suy tim do suy chức năng bơm máu của tim với đặc điểm phân số tống máu EF nhỏ hơn 45%. Trong suy tim tâm thu, khả năng co bóp của thất trái giảm làm cho thể tích tống máu không đầy đủ khiến cung lượng tim giảm. Nguyên nhân do tế bào cơ tim mất chức năng hoặc bị hủy hoại. Cơ chế thường gặp là thiếu máu cơ tim, nhồi máu cơ tim và sẹo hóa. Tế bào cơ tim còn bị hủy hoại bởi quá trình viêm (viêm cơ tim) hoặc thâm nhiễm (amyloidosis) hay trong các bệnh bẩm sinh như bệnh teo cơ Duchenne, cấu trúc phân tử của từng tế bào cơ tim bị rối loạn. Các chất độc và thuốc (như etanol, cocaine, amphetamines) là nguyên nhân gây tổn hại nội bào cơ tim. Tế bào cơ tim chết được thay thế bằng tổ chức sẹo đã gây ảnh hưởng nghiêm trọng đến chức năng của cơ tim. Trên siêu âm tim, hiện tượng này được thể hiện bằng hình ảnh rối loạn vận động hay không vận động từng vùng hoặc toàn bộ các thành tim.
Do tâm thất không được làm rỗng một cách thỏa đáng, áp lực cuối tâm trương và thể tích cuối tâm trương tăng lên. Áp lực này được truyền lên tâm nhĩ. Tại các buồng tim trái, áp lực tác động lên hệ mạch phổi làm tăng áp lực thủy tĩnh, tạo điều kiện thuận lợi cho máu dễ dàng thoát quản vào phế nang gây phù phổi cấp. Phía các buồng tim phải, áp lực được truyền ngược về phía hệ thống tĩnh mạch và mao mạch. Tại đây áp lực thủy tĩnh tăng cũng tạo điều kiện cho dịch trong lòng mạch tràn vào tổ chức của các cơ quan đích và các chi gây phù, nhất là hai chi dưới. Đây là bệnh rất nguy hiểm đến tính mạng, vì thế người bệnh cần tuân thủ đầy đủ chỉ định điều trị của thầy thuốc.
TS. Tạ Mạnh Long